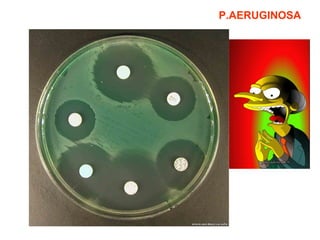
P.AERUGINOSA

The document summarizes common types of wound infections and the microorganisms that typically cause them. It discusses bacteria that can lead to infections from superficial injuries, severe wounds, wounds in water or tropical regions, surgical wounds, burns, bites, and other injuries. Common causes include Staphylococcus aureus, Streptococcus pyogenes, Pseudomonas aeruginosa, Clostridium tetani, Clostridium perfringens, and various mycobacteria, fungi, and anaerobes depending on the location and severity of the wound.